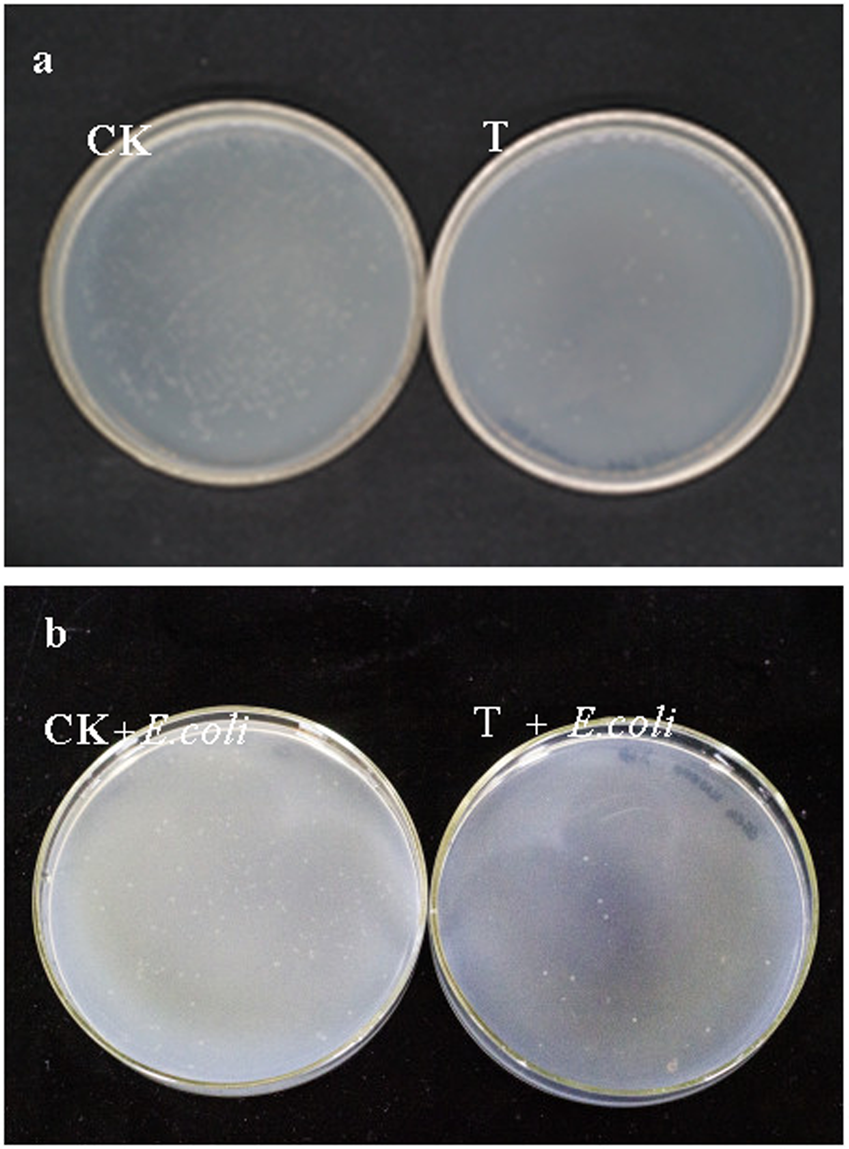
Figure 6

Figure 6
CFU analysis of difference in cultivable gut bacteria of E.obliqua larvae between control groups and EGCG treatment groups (n = 5). (a) Dilute to 1 × 105 times. CK: larvae feed on artificial diet; T: larvae feed on artificial diets containing 1% EGCG; (b) Dilute to 1 × 104 times. CK + E. coli: After larvae feed on artificial diets five days, we switched to feed on artificial diets containing 20 ml Escherichia coli for 24 hours; T + E. coli: after larvae feed on artificial diets containing 1% EGCG five days, we switched to feed on artificial diets containing 20 ml Escherichia coli for 24 hours.